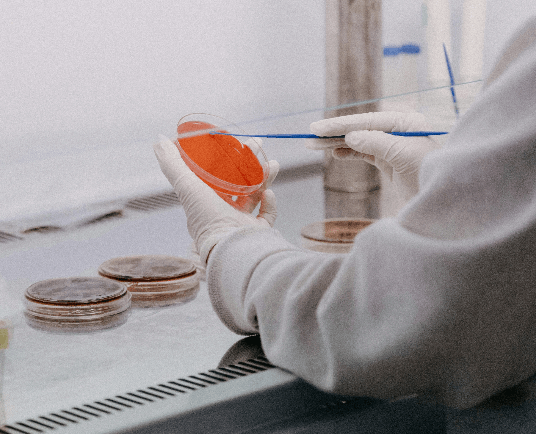

About Us
Our Company
At Pegasus Scientific and Laboratory Equipment, we are a leading company in the distribution and support of cutting-edge scientific instruments across Greece. With decades of expertise, we specialize in high-tech equipment for chemical analysis and the bio-sciences, ensuring that our customers have access to the best tools and services for their scientific needs.
Our comprehensive offerings include an organized sales department and a dedicated team for technical and scientific support, delivering end-to-end solutions from the distribution of products to post-installation services. We pride ourselves on not just providing top-tier instruments but also offering certified technical support and custom application development to ensure optimal performance of the systems we supply.
We are trusted partners for many of Greece’s most prominent industries, including pharmaceuticals, food production, petrochemicals, plastics, and materials science, as well as renowned R&D centers and certified laboratories. Our collaborations extend to academic institutions, research facilities, doping control, forensic science, and public laboratories in the private sector.
At Pegasus, we’re committed to advancing scientific progress by equipping our clients with reliable instruments and expert support, helping them to drive innovation and achieve excellence in their fields.
Our Story
The Pegasus Group began its journey in 1993, focusing on scientific and diagnostic equipment, medical devices, and the pharmaceutical sector, as well as laboratory services. Building on this foundation, Pegasos Scientific and Laboratory Equipment was established in 2016 in Greece, founded by experts with decades of experience in the field.
Since our inception, we have grown to serve major clients not only in Greece but also in Albania, Kosovo, and Cyprus, managing a range of significant projects across these regions. What started as a vision to expand into the broader Greek market became a reality, driven by a strategic partnership with Agilent Technologies. This success was followed by collaborations with industry leaders like Eppendorf, Ohaus, Gerstel, Mettler Toledo, and many more.

Today, our company is proud to have a team of over 30 specialized professionals, operating from three state-of-the-art facilities in Athens and Thessaloniki. With over 1,000 satisfied customers, we remain committed to delivering excellence in scientific and laboratory equipment and services across the region.
What is Our Mission
Our Vision
Pegasus aims to be the leading provider of innovative scientific solutions in Greece, driving progress by delivering cutting-edge technologies and exceptional support to laboratories, research centers, and industries. We empower our clients to push boundaries and achieve transformative breakthroughs across diverse sectors, including pharmaceuticals, biotechnology, environmental sciences, and healthcare.
By fostering a culture of excellence and collaboration with global leaders, we strive to set new industry standards and inspire innovation. Ultimately, our vision is to be recognized as a driving force in the scientific community, enabling groundbreaking discoveries that improve lives and contribute to a sustainable future.
Our Values
At Pegasus, our core values are rooted in innovation and excellence, embracing cutting-edge technologies that propel scientific advancement. We are dedicated to fostering collaboration with global industry leaders and valued clients to deliver the best possible scientific outcomes.
Integrity and honesty are at the heart of our business, guiding everything we do. While striving to be a key leader in the industry, we also prioritize creating a unique and supportive workplace environment for our employees.
Sustainability is a key focus for us, and we are committed to environmental responsibility in every aspect of our operations, ensuring we contribute to a healthier, more sustainable future.
Our Goals
At Pegasus, our goals are to solidify our position as the leading provider of scientific solutions in Greece and expand into international markets. We aim to continuously innovate by integrating cutting-edge technologies while delivering exceptional customer service through tailored support and certified technical assistance. Sustainability is a key focus, and we are committed to minimizing our environmental impact through eco-friendly practices. We also strive to foster a positive workplace that promotes employee growth and development. By strengthening strategic partnerships with global industry leaders, we aim to drive innovation and support breakthroughs in key sectors like pharmaceuticals, healthcare, and environmental sciences.
Our News
Careers
The future is YOU
At Pegasus Scientific and Laboratory Equipment, our people are our greatest asset. We foster a dynamic and inclusive workplace that promotes growth, collaboration, and innovation. As we work towards becoming the leading provider of scientific solutions in Greece, we seek passionate individuals eager to make a meaningful impact.
Joining our team means being part of a culture that values creativity and continuous learning. If you’re ready to push boundaries and drive scientific progress, explore our career opportunities and help shape the future of science with us.
Events & Webinars
At Pegasus, we actively participate in and organize events, conferences, and webinars to share knowledge, showcase innovations, and connect with the scientific community.
Through our seminars and online sessions, we aim to keep professionals updated on the latest technologies and best practices, while creating opportunities for learning and collaboration.
Stay tuned for our upcoming events and join us in advancing science together.





